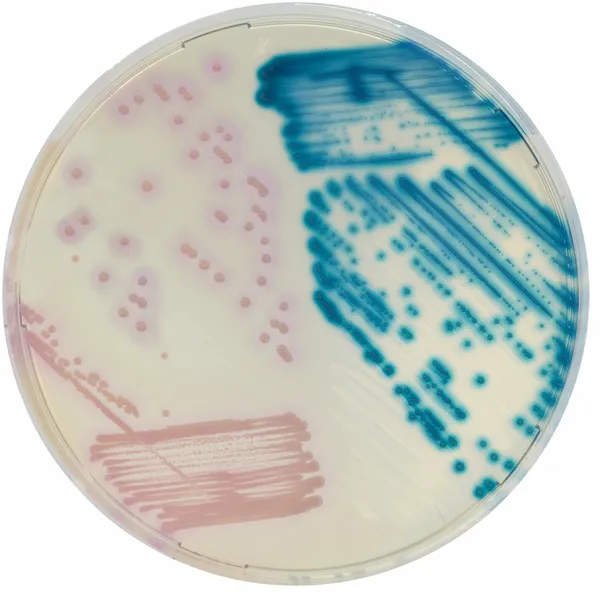
CHROMagar™ LIN-R

Hình thái khuẩn lạc

LZDR Enterococcus
màu xanh kim loại

LZDR S. aureus, S. epidermidis
màu hồng
Hiệu năng
Hiệu năng
Cocci Gram (+) gây ra mối đe dọa toàn cầu cho sức khỏe con người do sự nổi lên của kháng sinh. Linezolid có hoạt phổ rộng chống lại nhiều vi sinh vật gây bệnh Gram (+), như MRSA, VRS và VRE. Tuy nhiên, sự xuất hiện của các chủng kháng linezolid (LIN-R) và sự lan truyền ngang của kháng liên quan đến gen cfr đã được báo cáo tăng lên sau khi được phê duyệt sử dụng lâm sàng.
Mặc dù tỷ lệ kháng linezolid vẫn thấp, sự nổi lên của các chủng LIN-R vẫn là mối quan ngại lớn. Hiện nay, độ nhạy linezolid trong các mẫu lâm sàng Gram (+) chủ yếu được theo dõi bởi các chương trình giám sát ở Châu Âu và Hoa Kỳ. Các phân lập lâm sàng để giám sát các chủng LIN-R bao gồm các mẫu swab từ mũi (để sàng lọc Staphylococcus), vùng quanh hậu môn và trực tràng (để sàng lọc Enterococcus).
CHROMagar™ LIN-R là môi trường sàng lọc chromogenic để phát hiện, phân lập và phân biệt các chủng Staphylococcus và Enterococcus kháng linezolid.
1. Rất nhạy: Phát hiện MIC thấp tới 8 μg/mL.
3. Dễ diễn giải: Xác định loài bằng MALDI-TOF có thể thực hiện trực tiếp từ khuẩn lạc.
Thành phần

Tài liệu kỹ thuật
Công bố khoa học
2023
CHROMAgar™ LIN-R as an efficient screening tool to assess the prevalence of linezolid-resistant enterococci in German hospital patients—a multicentre study approach, 2021–2022
? Publication2023
Results of the German multicenter study using CHROMagar™LIN R to detect linezolid resistant enterococci
? Publication2022
Evaluation of CHROMagar™ LIN-R for the Screening of Linezolid Resistant Staphylococci from Positive Blood Cultures and Nasal Swab Screening Samples
? Publication2022
Dépistage de la résistance au linézolide : évaluation d’un milieu chromogène sélectif
? Publication2021
Excellent performance of CHROMagar LIN-R to selectively screen for linezolid-resistant enterococci and staphylococci
? Publication2021
Prevalence of linezolid-resistant organisms among patients admitted to a tertiary hospital for critical care or dialysis
? Publication

Xem thêm